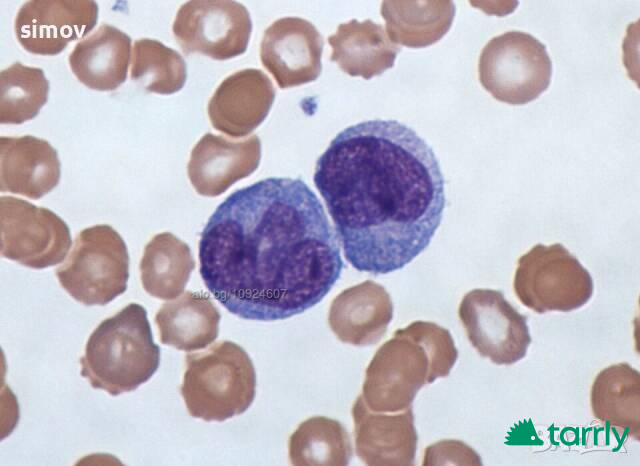
Снимка номер 1 за Азур-еозин по Романовски 99 прах-багрило за микроскопскопия.
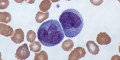
Снимка номер 1 за Азур-еозин по Романовски 99 прах-багрило за микроскопскопия.

Азур-еозин по Романовски 99 прах-багрило за микроскопскопия.
Оцветяването по Романовски е прототипна техника за оцветяване, която е предшественик на няколко различни, но подобни оцветители, широко използвани в хематологията (изследване на кръвта) и цитопатологията (изследване на болни клетки).
Оцветителите от типа Романовски се използват за диференциране на клетки за микроскопско изследване в патологични проби, особено кръвни и костномозъчни филми и за откриване на паразити като малария в кръвта.
Цена - 2 евро/гр. и куриерски
За автора
Мнения от други потребители